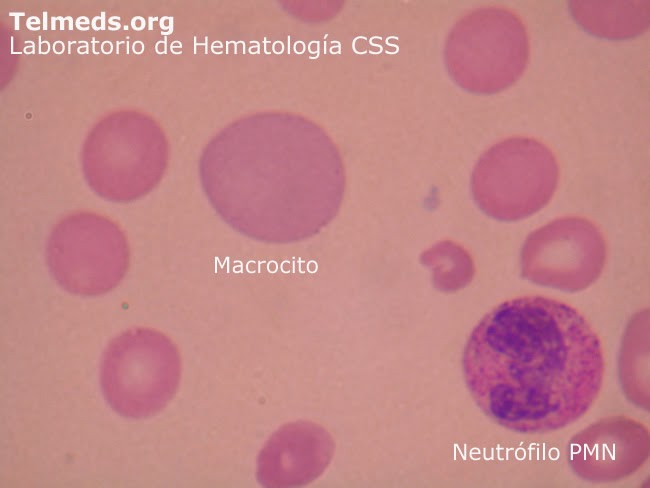

> TAMAÑO: Si el diámetro de los
hematíes supera las 8.5 o 9 micras se dice que son macrocíticos.
> DESCRIPCIÓN
DEL NÚCLEO Y CITOPLASMA: Si sólo se advierten unos cuantos glóbulos de este tipo,
el VCM estará dentro de los límites normales, pero en la mayor parte de las
anemias megaloblásticas no tratadas, el VCM suele rebasar los 105 fL. La
macrocitosis es normal en el recién nacido y el lactante. Si existe gran número
de reticulocitos en la extensión de sangre periférica, se distinguen
macrocitos, porque los reticulocitos son mayores que los glóbulos rojos
adultos.
> SITIO DEL
CUERPO EN DONDE SE ENCUENTRA: sangre periférica.
> ENFERMEDAD
EN LA QUE SE ENCUENTRA: Generalmente, la macrocitosis es característica del
déficit de folato o vitamina B12. La macrocitosis de la anemia
perniciosa suele ser ovoides. (Miale, 1985).
No hay comentarios.:
Publicar un comentario